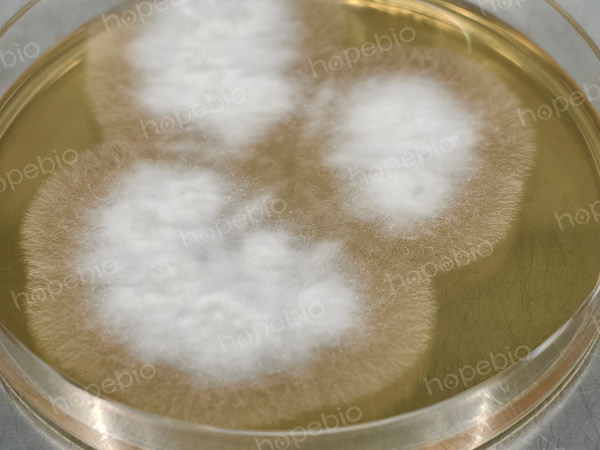
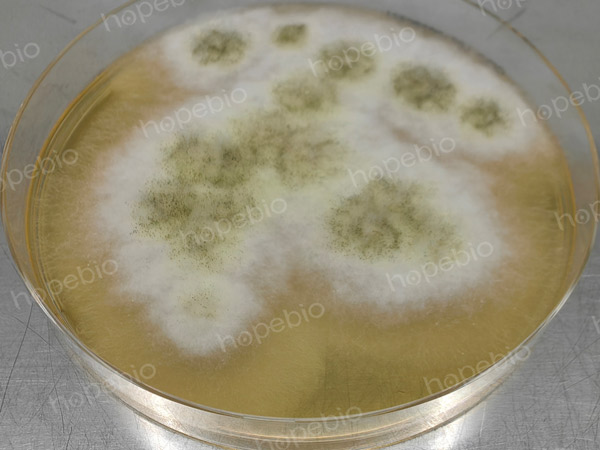
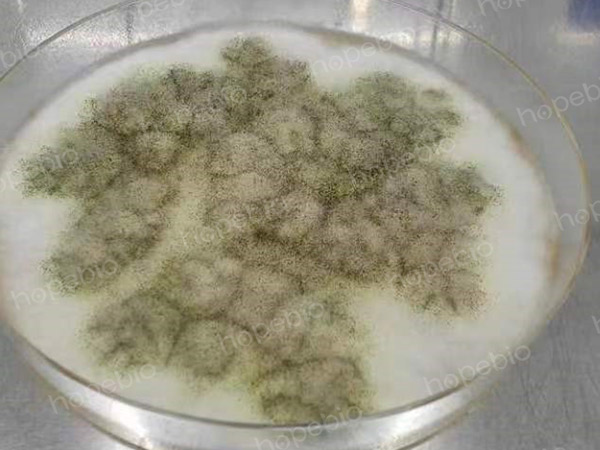
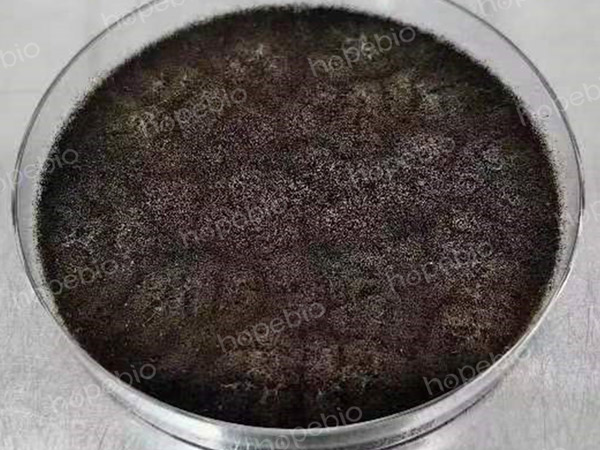

海博微信公众号
海博微信公众号
 海博天猫旗舰店
海博天猫旗舰店


 海博微信公众号
海博微信公众号
 海博天猫旗舰店
海博天猫旗舰店




一、黑曲霉简介
黑曲霉(Aspergillus niger)为曲霉属真菌中一个常见种,在自然界中广泛存在,生命力强,在马铃薯葡萄糖琼脂或沙氏葡萄糖琼脂上生长初期产生白色菌丝,长大后逐渐变黄,随着培养基内营养的不断消耗,菌丝的顶端逐渐产生灰黑色的孢子。
二、活化方法
黑曲霉的活化可以使用沙氏葡萄糖液体/琼脂培养基、马铃薯葡萄糖琼脂/马铃薯葡萄糖水等常用的真菌类培养基,也能在胰酪胨大豆琼脂、营养琼脂等细菌培养基上生长,而实验室培养黑曲霉通常需要用到孢子进行各种测试,一般建议使用固体培养基(SDA或PDA)进行活化。
注:若需要用到黑曲霉的孢子,通常需培养至较长时间(一般为5-7天左右)可产生丰富的孢子,选择较低营养的培养基有时候可以更快获得孢子,培养时还需注意保持良好的透气性,有助于霉菌的快速生长和孢子的产生。
培养初期,黑曲霉产生白色菌丝,向周围扩散生长
培养时间延长,培养基内营养逐渐被耗尽,菌丝颜色开始变黄色,并开始产生少量孢子
产孢子量逐渐增加
培养结束后,菌丝顶端产生大量黑色孢子
三、实验室常用保存方法
1.斜面保存法
将SDA或PDA制成斜面管,接种黑曲霉后培养至产生丰富孢子,置于2-8℃可保存3-6个月或更长时间,若在表面覆盖无菌液体石蜡隔绝空气和减少水分蒸发,保存时间可延长至一年以上。
2.甘油冷冻保存法
可将黑曲霉的孢子悬液加入至甘油保存管中(甘油浓度通常为20%左右,也可使用商品化的液体菌种保存管),置于-70℃以下冷冻保存,一般可稳定保存两年至数年。
3.瓷珠菌种保存法
将黑曲霉的孢子转移至瓷珠菌种保存管中,上下颠倒数次,舍弃管内液体,将瓷珠冷冻保存与-20℃或-70℃以下冰箱或液氮罐中,可长期存活(一般在-20℃至少存活一年以上,在-70℃至少存活两年以上)。
注:黑曲霉的活化和保存通常使用孢子部分。在进行转接培养时,一般需挑取黑曲霉的孢子体转接至另一培养基中进行培养,进行甘油或瓷珠冷冻保存时,也应保存黑曲霉的孢子体。
四、孢子悬液的制作
在进行培养基的灵敏度检验或者做一些霉菌杀灭效果试验时,通常需要用到黑曲霉的孢子悬液。可将沙氏葡萄糖琼脂或马铃薯葡萄糖琼脂制成斜面培养基(如需要得到大量孢子悬液,可使用锥形瓶制大斜面),接种黑曲霉,培养至产生丰富的孢子,加入一定体积的洗脱液(可用生理盐水、0.1%蛋白胨水、磷酸盐缓冲液等)对斜面进行冲洗,得到高浓度的混悬液,将混悬液通过无菌棉花或纱布进行过滤,除去悬液中可能混入的菌丝体,便可得到孢子悬液。制备好的孢子悬液可放置于2-8℃,在验证过的有效期内保存及使用。
相关产品:
注:本文属海博生物原创,未经允许不得转载。
下一篇:浅谈如何抑制变形杆菌的迁徙生长
| 相关文章: | |



